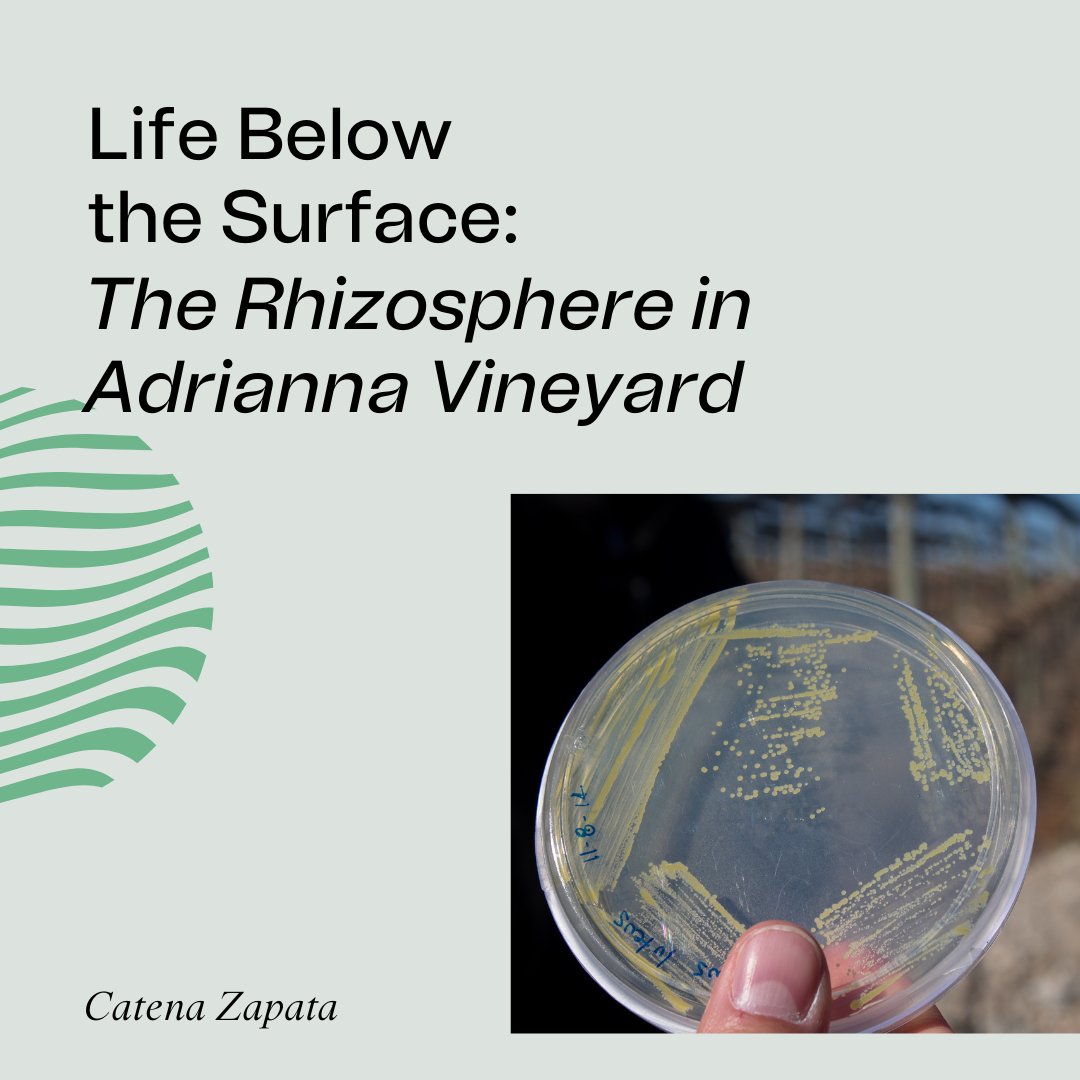
ProtocolPorto's tweet image. DID YOU KNOW that bacteria living around the roots have proved to be quite important to the development and growth of plants?

The Porto Protocol foundation
@ProtocolPorto
The Porto Protocol Foundation is on a quest to bring together a network of changemakers and workable climate solutions within and for the wine world.
قد يعجبك
Reduce, Reuse, RETHINK by @ProtocolPorto climateweeknyc.org/events/reduce-…
‘Water-Clever Vineyards’, our next Climate Talk’, is on June 7th, 4pm UTC. It's the 1st of a series of initiatives exploring #watermanagement. Rosa Kruger, Joan Esteve Julià and Luis Reginato speak to Sushma Shankar. Link to register: shorturl.at/uwCW1Watch live or later.

Wine Law & Sustainability, May 10th, 6pm UTC, in partnership with @catolicaporto. With Allison Jordan (@CalifWines_US; Bennett Caplan (FIVS) and @LuisAmadoDurao. Registration: lnkd.in/debszeWJ

Thank you @TheBuyer11 and @richardsiddle for such a comprehensive coverage of our bold and pioneering initiative with Sustainable Wine Solutions (Borough Wines) and the London Wine Fair. Thank you both organizations for this collaboration. #climatechange #wine
With over 30k glass bottles set to be used at @londonwinefair how can it live up to its main sustainability agenda? By introducing a new, breakthrough glass bottle reuse scheme. Here @ProtocolPorto & @sws_wine explain how it is going to work the-buyer.net/insight/london…

Our next Climate Talk - Business Edition is coming on April 20th at 5 pm UTC on "#Sustainability and #Profitability" with guests Steven Campbell, Dom de Ville and Melissa Saunders MW. Save the date and register to participate live: us02web.zoom.us/webinar/regist…

Our next Climate Talk is coming on March 2nd on "Biochar as a climate mitigation tool?" with Mimi Casteel, Claudia Kammann, Hans-Peter Schmidt and Antoine Lespès at 5pm UTC. Save the date and register to participate live: us02web.zoom.us/webinar/regist…

On Feb 23rd at 5:30pm UTC, in our next Climate Talk, Jérémy Cukierman MW, Hans Schultz and Dario Cantù will talk to Greg Jones about how universities and wine schools are adapting their curriculums to a changing climate. Register here: us02web.zoom.us/webinar/regist…

Our next Climate Talk is coming on January 25th on Discovering the world of vineyard #microbes with Tom Croghan, Kees Van Leeuwen, Andreia Figueiredo, Alex Gobbi and a live audience of students from UTAD. Save the date and register to participate live: us02web.zoom.us/webinar/regist…

Tomorrow, Dec 13th at 4pm UTC, the "Characterization and Paths to Multiregional #Sustainability" presentation will take place in a hybrid event with the Viticulture Commission of Bairrada, Beira Interior, Dão, Lisbon and Tejo. Link to register: us06web.zoom.us/webinar/regist…

Tomorrow, Nov 29th at 5pm UTC, in our next Climate Talk, Michele Manelli, Patricia Berardi and Stephanie Barger will talk to Marta Juega about #waste management and #circularity. Register here: us02web.zoom.us/webinar/regist…

A Review Protocol. An Expert Panel. A new Regional Representative. And a great leap forward - mailchi.mp/3494e6a37032/o…
Yesterday, October 24th, the world celebrated the International Day against Climate Change. A day after, or rather, everyday, will you share one action you are implementing to mitigate it?

Tomorrow, Sept 22nd 5pm UTC, Carmel Kilcline MW (@marksandspencer), Marcus Ihre (@systembolaget) and @ScotCase (National Retail Federation), will be discussing he role of retailers as drivers of #Climate Action. Register: us02web.zoom.us/webinar/regist…

Watch the full documentary here: youtube.com/watch?v=EJhnaJ… Join the Porto Protocol community now!

youtube.com
YouTube
Climate Change Leadership - The Documentary
There is no denying Climate Change. In the past weeks, we have been witnessed the heatwaves and horrible wildfires raging across Europe. But we are filled with hope! Our members are fully commited into tackling the Climate Change with all kinds of solutions!
Reimagining Box Wine for the Sake of the Planet – an article by Melissa Saunders MW




Reimagining Box Wine for the Sake of the Planet – an article by Melissa Saunders MW portoprotocol.com/case-studies/r…
Welcome Maison Mirabeau to the community! @MaisonMirabeau Mirabeau believes that, as wine producers, they need to tread lightly and do everything they can to reduce the impact of farming, supply chain and global logistics on the environment.


DID YOU KNOW that bacteria living around the roots have proved to be quite important to the development and growth of plants?

Last week, @ProtocolPorto released a documentary that profiles a few of its more than 220 members in 16 countries. Dodon is humbled to be among those that are highlighted. Take a look here :youtube.com/watch?v=EJhnaJ…

youtube.com
YouTube
Climate Change Leadership - The Documentary
United States الاتجاهات
- 1. Colts 14.8K posts
- 2. Jameis 4,841 posts
- 3. Arsenal 338K posts
- 4. #ChiefsKingdom 2,413 posts
- 5. Mason Rudolph 3,760 posts
- 6. #HardRockBet 4,101 posts
- 7. #HereWeGo 2,733 posts
- 8. Tottenham 104K posts
- 9. #ARSTOT 20.5K posts
- 10. Thomas Frank 10.8K posts
- 11. Nahshon Wright N/A
- 12. #GoPackGo 2,364 posts
- 13. Jawaan Taylor N/A
- 14. Wan'Dale Robinson N/A
- 15. Go Birds 8,847 posts
- 16. Dallas Turner N/A
- 17. DJ Moore 1,006 posts
- 18. St Brown 1,131 posts
- 19. Eberechi Eze 25.4K posts
- 20. Richarlison 12.4K posts
Something went wrong.
Something went wrong.






















































































































